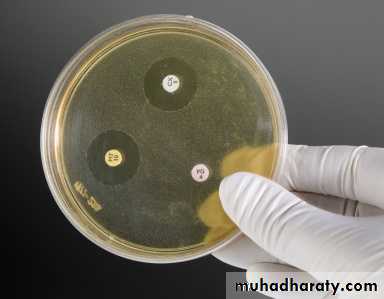
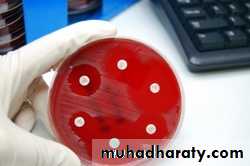
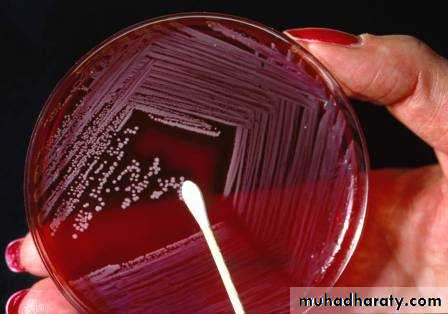
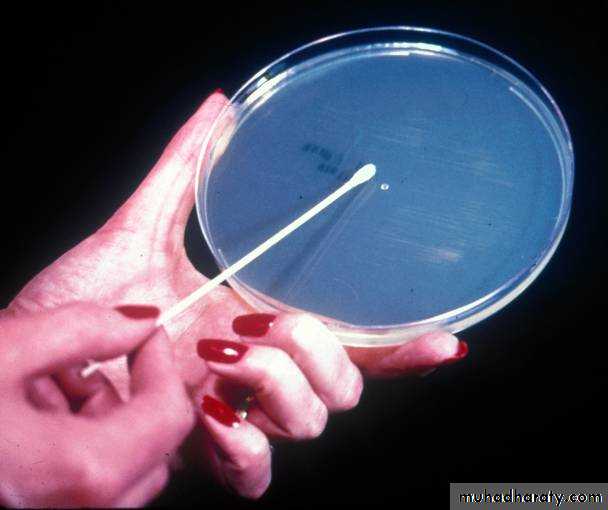
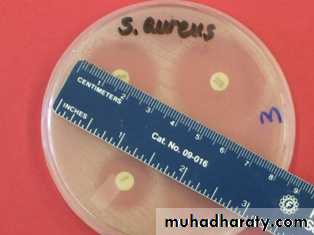

Lab: 6 ANTIBIOTIC SENSITIVITY TESTING
1Antibiotic sensitivity test : a laboratory test use to measure the ability of an antimicrobial agent to inhibite the growth of m.o in vitro this test will assist the clinicians in the choice of drug for treatment of infections in vivo.
2
Definition and uses of antibiotic sensitivity testing
Sensitive
IntermediateResistant
3
According to this the m.o classified into 3 categories
Sensitive: An organism is called sensitive to an antimicrobial agent when the infection caused by it is likely to respond to treatment with that particular antimicrobial agent at the recommended dose.
Intermediate: This term is applicable to strains that are moderately suscepitable to an antimicrobial agent that can be used for treatment at higher dose (if it has a low toxicity or the antimicrobial agent is concentrated in the focus of infection as in urine). But if the antimicrobial agent was toxic in high dose then other measure should be use as it can use in combination with other agent.
Resistant :An organism is not to respond to a given antimicrobial agent irrespective of the dose and the location of the infection.
4
5
The main purposes of susceptibility (sensitivity) test
As a guide for treatment
It helps the physician in selecting the best antimicrobial agent for patients .
As an epidemiological tool
The emergence of resistant strains of major pathogens (e. g. Shigella, Salmonella typhi)
Continued surveillance of the susceptibility pattern of the prevalent strains (e. g. Staphylococci, Gram-negative bacilli)
Which organisms to test?
What methods to use?What antibiotics to test?
How to report results?
What Does the Laboratory Need to Knowabout Antimicrobial Susceptibility Testing (AST) ?
6
Susceptibility Tests
There are 4 methods to perform the antibiotic sensitivity test :1- disc diffusion
2- broth dillution
3- E- test
4- vitek 2 test
7
The principle of disc agar –diffusion method:
Dependent upon the inhibition of reproduction of a m.o on the surface of a solid medium by an antimicrobial agents which diffuses into the medium from a filter paper disc into the medium . If the organism is killed or inhibited by the concentration of the antibiotic , there will be no growth in the immediate area around the disc : this is called the zone of inhibition .8
1- Disc agar –diffusion (Kirby-Bauer) test
1-The media: Muller –Hinton , nutrient agar or blood agar
2-Antimicrobial discs: commercially available disc are used but chossing the appropriate antibiotic for routine susceptibility tests is as follow:Drugs for routine susceptibility tests:
Set 1: the drugs that are available in most hospitals and for which routine testing should be carried out for every strain
Set 2: the drugs that are tested only:
at the special request of the physician
or when the causative organism is resistant to the first-choice drugs
or when other reasons (allergy to a drug, or its unavailability) make further testing justified
3- the sample: a bacterial sample ,after isolation and identification of bacteria precede the selection of antibiotic testing method
4- sterile cotton swab
9
Materials and reagents
10
Table 1: Basic sets of drugs for routine susceptibility
• Set 1
• Set 2
• Staphylococcus
• Benzyl penicillinOxacillinErythromycinTetracyclineChloramphenicol
• GentamicinAmikacinCo-trimoxazoleClindamycin
• Intestinal
• AmpicillinChloramphenicolCo-trimoxazoleNalidixic acidTetracycline
• Norfloxacin
• Enterobacteriaceae
• Urinary
• SulfonamideTrimethoprimCo-trimoxazoleAmpicillinNitrofurantoinNalidixic acidTetracycline
• NorfloxacinChloramphenicolGentamicin
• Blood and tissues
• AmpicillinChloramphenicolCotrimoxazoleTetracyclineGentamicin
• CefuroximeCeftriaxoneCiprofloxacinPiperacillinAmikacin
• Pseudomonas aeruginosa
• PiperacillinGentamicinTobramycin
• Amikacin
11
Disc Diffusion Method
Procedure
1- Prepare the inoculum : 108 CFU/ml bacterial inoculum in nutrient broth which is prepared by Picking 3-5 isolated colonies from the plate
2-Adjust the turbidity to the same as the McFarland No. 0.5 standard.*
3-Dipping a sterile swab into the broth
4-Streak the swab on the surface of the Mueller-Hinton agar or nutrient agar (3 times in 3 quadrants)
5-Leave 5-10 min to dry the surface of agar which allowing the bacteria to establish themselves on the media.
6-Place the appropriate drug immpregnant disc on the surface of the inoculated agar plate.
7-Invert the plate and incubate them at 37ºC for (18-24 h).12
Disk Diffusion Test
Select colonies
Prepare inoculum
suspensionPrepare inoculum
suspension
13
Prepare the Material for Inoculation
Standardize inoculum
Suspension as per Mac farland standardMix well
Nadia A. Hussin14
Swab the plate with optimal sample
Remove sample
Swab plate15
Select the Disks and Apply
Select disks
16Incubate Overnight
1718
• 8-Reporting the Results
• By comparing the diameters with “standard tables” as the bacteria on the media grow, they are inhibited to vary degree by the diffusing from the disc.• 1-zone size differ on sensitivity pattern (varies for antibiotic correlated with sensitivity or resistant to the antibiotic tested.
• 2-look at the chart for establishing the zone of sensitivity: the zone size are looked up on a standerdized chart to give a result of sensitivity ,resistane, or intermediate .
• 3-Read the result : Place the metric ruler across the zone of inhibition, at the widest diameter and measure from one one edge of the zone to the other edge. The disc diameter will actually be part of the number . Zone diameter result reported in milimeter , looked up on the chart and result reported as sensitive (S), resistant (R) ,or intermediate (I).
Transmitted
Light19
20
21
Limitation of disc diffusion methods Disc diffusion methods are not suitable for slow growing bacterial pathogens.
22
Dilution antibiotic sensitivity test
a laboratory test used to determine the minimum concentration of antibiotic that required to control the infection (complete inhibition of the m.o)
Minimum Inhibition Concentration (MIC)
The lowest concentration of antimicrobial agent that inhibits bacterial growth/ multiplication
Minimum Bactericidal Concentration (MBC) or Minimum Lethal Concentration (MLC)
The lowest concentration of antimicrobial agent that allows less than 0.1% of the original inoculum to survive
23
Broth Dilution Method
Procedure
Making dilutions (2-fold) of antibiotic in broth Mueller-Hinton, or nutrient broth (e.g , 1,2,4,8,16 µg/ml) in a liquid medium dispensed in test tube.
1-Transfer 2 ml of each antibiotic dispensed in test tubes.
2-The antibiotic containing tubes were inoculate with standardized bacterial suspension of the McFarland No. 0.5 standard.*
3-Following overnight incubation at 37ºC ,the tubes were for visible bacterial growth as evidence by turbidity.
4-The lowest concentration of antibiotic that prevented growth represented the minimal inhibitary concentration
5-Controls: no inoculum, no antibiotic
6- read the result :by culturing the tube of no turbidity on a suitable agar plate overnight.
Turbidity visualization MIC
Sub culturing of non-turbid tubes, overnight
Growth (bacterial count) MBC
24
Broth Dilution Method
64 32 16 8 4 2 1 C1 C2
0.01 ml (spread plate), Incubate 35 oC, o/n
64 32 16
AdvantageMore accurate than the disc diffusion method
Can be used for academic purpose
Disadvantages :
Only one antibiotic & one organism can be tested each time
Time-consuming
Broth dilution method are technically difficult
It is very expensive
25
Broth Dilution
26
3-E-test
E-test is a well established AST method in microbiology laboratories around the world. The Etest technique comprises a predefined gradient of antibiotic concentrations on a plastic strip, and can be used to determine the Minimum Inhibitory Concentration (MIC) of antibiotics.
27
MIC of the Bacteria can be read Directly
Antibiotic Sensitivity testing can be done with automation
28
29
4-VITEK 2 system Reporting of Resistance
VITEK 2 system is the Advanced Expert System (AES™), a software which interprets susceptibility test results, and detects antibiotic resistance mechanisms. The AES Expert System is the most developed software system in this field, and is capable of identifying even low-level resistance.